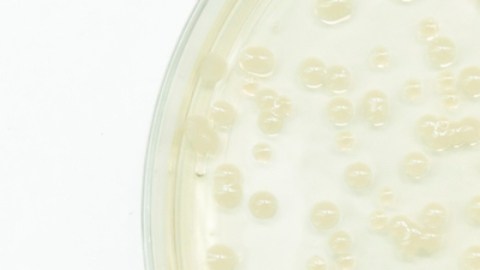

Avanza el desarrollo de un nuevo antibiótico para luchar contra las superbacterias
El Emblaveo, un nuevo antibiótico desarrollado por Pfizer y Abbvie en colaboración con entidades públicas, ofrece una esperanza en la lucha contra las superbacterias al tratar infecciones resistentes
Se trata de un nuevo antibiótico desarrollado por Pfizer y Abbvie. Crédito: unoL | Shutterstock
La lucha contra las superbacterias ha sido una batalla continua en el campo de la medicina durante décadas, con más de 1,2 millones de muertes registradas anualmente a nivel mundial. Esta guerra parece ser interminable debido a la resistencia biológica inherente de los microorganismos.
Aunque se desarrollen tratamientos efectivos, la selección natural siempre conduce al surgimiento de cepas resistentes cuando se utilizan de manera extensiva.
Sin embargo, se ha adoptado una estrategia de ganar tiempo, enfocada en la prevención de nuevas infecciones, el uso prudente de antibióticos y el desarrollo constante de nuevos medicamentos para contrarrestar las resistencias emergentes.
Recientemente, la Comisión Europea ha autorizado la comercialización de Emblaveo, un nuevo antibiótico desarrollado por Pfizer y Abbvie en colaboración con la Unión Europea y los Estados Unidos.
Este medicamento está dirigido al tratamiento de infecciones intraabdominales y urinarias complicadas, así como neumonías hospitalarias, causadas por ciertos tipos de bacterias gramnegativas que han desarrollado resistencia a tratamientos convencionales. El Emblaveo es una combinación de aztreonam y avibactam, representa una nueva arma en la lucha contra las superbacterias, especialmente aquellas resistentes a múltiples fármacos.
El desarrollo del Emblaveo se basó en la colaboración entre el sector público y la industria farmacéutica, con importantes inversiones y apoyo financiero por parte de la Unión Europea a través de proyectos como COMBACTE-CARE.
Este enfoque colaborativo ha permitido realizar ensayos clínicos significativos, como REJUVENATE y REVISIT, que han demostrado la eficacia y seguridad del Emblaveo en el tratamiento de infecciones graves causadas por bacterias gramnegativas.
Uno de los aspectos destacados del Emblaveo es su capacidad para inhibir la actividad de las enzimas betalactamasas, que las bacterias utilizan para desactivar ciertos tipos de antibióticos. El avibactam, uno de los componentes del Emblaveo, es especialmente efectivo contra ciertas clases de betalactamasas, lo que amplía su espectro de acción y lo hace más eficaz contra cepas bacterianas resistentes.
Este enfoque innovador ha sido fundamental para superar algunas de las limitaciones de los tratamientos antibióticos existentes.
A pesar de los avances en el desarrollo de nuevos medicamentos, persisten desafíos significativos en la lucha contra las superbacterias. El uso indiscriminado de antibióticos sigue siendo una preocupación, ya que puede acelerar el desarrollo de resistencias bacterianas.
Por lo tanto, es crucial promover prácticas de prescripción responsable y educar al público sobre la importancia de completar los tratamientos antibióticos según lo prescrito.
Además, la falta de interés de la industria farmacéutica en el desarrollo de nuevos antibióticos ha sido un obstáculo importante. Sin embargo, iniciativas como el IMI han contribuido a impulsar la investigación y el desarrollo en este campo, proporcionando incentivos económicos y no económicos para la creación de nuevos medicamentos.
El Emblaveo representa un avance significativo en la lucha contra las superbacterias, pero se necesitan esfuerzos continuos para abordar este desafío global de manera efectiva. La colaboración entre el sector público y privado, junto con una mayor conciencia sobre el uso responsable de los antibióticos, son fundamentales para contener la propagación de las resistencias bacterianas y garantizar el éxito de las terapias antimicrobianas en el futuro.
Sigue leyendo: